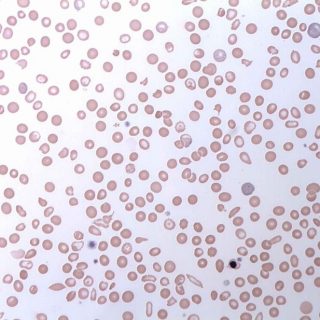

ACCEL Program Launched to Improve Healthcare Access for Sickle Cell Patients
By CATRINA SILVA Global Blood Therapeutics (GBT) intends to improve access to high-quality healthcare for people with sickle cell disease (SCD) in the U.S. through the recently launched Access to Excellent Care for Sickle Cell Patients Pilot Program (ACCEL). The company will donate up to $150,000 to speed the development of promising programs aimed...

Recent Comments